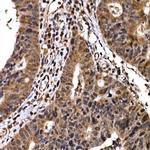
BTRC Antibody in Immunohistochemistry (Paraffin) (IHC (P))

Search
Invitrogen
BTRC Polyclonal Antibody
{{$productOrderCtrl.translations['antibody.pdp.commerceCard.promotion.promotions']}}
{{$productOrderCtrl.translations['antibody.pdp.commerceCard.promotion.viewpromo']}}
{{$productOrderCtrl.translations['antibody.pdp.commerceCard.promotion.promocode']}}: {{promo.promoCode}} {{promo.promoTitle}} {{promo.promoDescription}}. {{$productOrderCtrl.translations['antibody.pdp.commerceCard.promotion.learnmore']}}

Please note: We are reviewing Western blot images included in the antibody testing data in our catalog, including those provided by third parties. Unless expressly labeled or annotated as “raw-unedited”, Western blot images included in the antibody testing data in our catalog may have been edited, optimized or otherwise adjusted for presentation.
产品信息
PA5-109459
种属反应
宿主/亚型
分类
类型
抗原
偶联物
形式
浓度
规格
纯化类型
保存液
内含物
保存条件
运输条件
RRID
产品详细信息
Immunogen sequence: MDPAEAVLQE KALKFMCSMP RSLWLGCSSL ADSMPSLRCL YNPGTGALTA FQNSSEREDC NNGEPPRKII PEKNSLRQTY NSCARLCLNQ ETVCLASTAM
靶标信息
This gene encodes a member of the F-box protein family which is characterized by an approximately 40 amino acid motif, the F-box. The F-box proteins constitute one of the four subunits of ubiquitin protein ligase complex called SCFs (SKP1-cullin-F-box), which function in phosphorylation-dependent ubiquitination. The F-box proteins are divided into 3 classes: Fbws containing WD-40 domains, Fbls containing leucine-rich repeats, and Fbxs containing either different protein-protein interaction modules or no recognizable motifs. The protein encoded by this gene belongs to the Fbws class; in addition to an F-box, this protein contains multiple WD-40 repeats. This protein is homologous to Xenopus bTrCP1, yeast Met30, Neurospora Scon2 and Drosophila Slimb proteins. It interacts with HIV-1 Vpu and connects CD4 to the proteolytic machinery. It also associates specifically with phosphorylated IkappaBalpha and beta-catenin destruction motifs, probably functioning in multiple transcriptional programs by activating the NF-kappaB pathway and inhibiting the beta-catenin pathway.
仅用于科研。不用于诊断过程。未经明确授权不得转售。
篇参考文献 (0)
生物信息学
蛋白别名: beta-transducin repeat containing protein; Beta-transducin repeat-containing protein; Beta-TrCP; Beta-TrCP protein E3RS-IkappaB; btrc; E3RSIkappaB; Epididymis tissue protein Li 2a; F-box and WD repeats protein beta-TrCP; F-box/WD repeat-containing protein 1A; HOS; mE3RS-IkappaB; pIkappaB-E3 receptor subunit; pIkappaBalpha-E3 receptor subunit; SCF b-TRCP; Ubiquitin ligase FWD1
基因别名: b-TrCP; beta-TrCP; Beta-Trcp1; BTRC; BTRCP; E3RS-IkappaB; E3RSIkappaB; Fbw1; FBW1A; Fbxw1; FBXW1A; FWD1; HOS; Kiaa4123; Slimb
UniProt ID: (Mouse) Q3ULA2
Entrez Gene ID: (Mouse) 12234, (Rat) 361765




